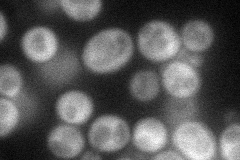
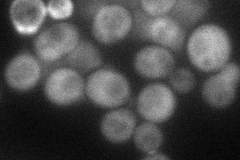
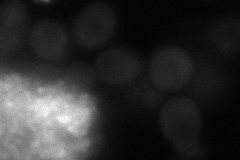
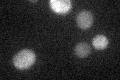

View description
Guanine nucleotide exchange factor (GEF) that functions to modulate Rho1p activity as part of the cell integrity signaling pathway; multicopy suppressor of tor2 mutation and ypk1 ypk2 double mutation; potential Cdc28p substrate
Localization:
Intensity:
Fold change:
Significance:
-
C’ GFP library in SD

cytosol22.37 -
N' NOP1pr-GFP in SD
cytosol48.8221 -
N' TEF2pr-mCherry in SD
cytosol45.8284 -
N' NATIVEpr-GFP in SD

below threshold16.8784 -
N' TEF2pr-VC and Cyto-VN in SD
cytosol37.4629 -
C’ GFP library in SD+DTT

cytosol19.60.87No -
C’ GFP library in SD+H2O2

cytosol26.041.16No -
C’ GFP library in Starvation Media
cytosol20.860.93No -
C’ GFP library on the background of Pup2-DaMP

cytosol -
C’ GFP library on the background of CCT mutant

cytosol20.95890.936481No
